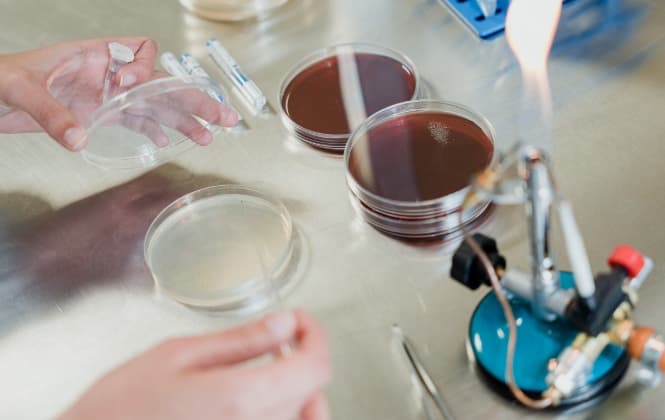
Especificaciones

Descubre Reprotext
Software para identificar el momento idóneo para realizar la inseminación

Soporte Reprotext
Teléfono
974 231 165
software@humeco.net
¿Qué es Reprotext?
Reprotext es un software avanzado que predice el estado reproductivo de los animales en tiempo real mediante ecografía externa no invasiva e inteligencia artificial. Está diseñado para porcino, bovino y equino, y ofrece ventajas como la generación de informes personalizados, el seguimiento histórico de cada animal y el acceso a los datos desde aplicación móvil o web con sincronización en la nube.
¿Qué mide Reprotext?
Mediante la colocación de una sonda en la superficie vulvar de la hembra, el software analiza las imágenes ecográficas y determina:
Momento de la ovulación
Identifica los cambios en el tejido vulvar y en el flujo sanguíneo que marcan el momento para la inseminación.
Estado del celo
Diferencia con precisión si la hembra se encuentra en fase de celo, preovulatoria o postovulatoria.
Gestación temprana
Permite confirmar de manera temprana la efectividad de la inseminación, para mejorar la gestión reproductiva.
Saca el máximo partido a Reprotext con el ecógrafo Duo-Scan:Go
El Duo-Scan:Go es un ecógrafo portátil ultraligero desarrollado para el diagnóstico reproductivo en granja. Especialmente diseñado para porcino, ovino y caprino, este dispositivo permite detectar gestación de forma rápida y precisa, facilitando la toma de decisiones en el manejo reproductivo.
Gracias a su tecnología inalámbrica, el ecógrafo transmite la señal vía WiFi y ofrece al usuario la posibilidad de elegir el método de visualización más cómodo: gafas, pantalla externa, visor de muñeca o teléfono móvil.
Especificaciones de Reprotext
Especificaciones de Reprotext
- Diagnóstico en tiempo real y no invasivo: Utiliza ecografía externa junto con inteligencia artificial para medir el estado reproductivo de hembras de porcino, bovino y equino.
- Indicadores validados científicamente: El software trabaja con dos marcadores de edema vulvar y un marcador de flujo sanguíneo en la arteria dorsal del clítoris, que permiten predecir ovulación, celo y gestación temprana.
- Compatibilidad con ecógrafos portátiles: Validado con equipos como Exapad Mini y Duo Scan Go.
- Informes personalizados y seguimiento histórico: permite generar informes personalizados y consultar los resultados desde la aplicación, con la posibilidad de almacenar el historial de cada animal.

Especificaciones de Duo-Scan:Go
Especificaciones de Duo-Scan:Go
- Conectividad: transmisión WiFi compatible con móvil, tablet, gafas o visor de muñeca.
- Multiusuario: hasta 3 equipos conectados a la vez.
- Autonomía: batería con duración de aproximadamente 2 horas de trabajo continuado.
- Resistencia: carcasa sellada, resistente al agua.
- Aplicación móvil: descarga gratuita para gestionar las imágenes y facilitar el diagnóstico.
¿Está interesado en Reprotext?
Rellena este breve formulario con tus datos y nos pondremos en contacto contigo lo antes posible.




